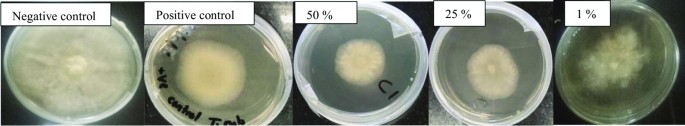
figure 3

- Research
- Open access
- Published:
Chemical profiling of antifungal Dicerocaryum senecioides and Diospyros mespiliformis extracts using TLC-p-iodonitrotetrazolium violet assay and GC–MS/MS
Future Journal of Pharmaceutical Sciences volume 9, Article number: 112 (2023)
Abstract
Background
Despite the availability of conventional medication for fungal skin diseases, dermatophytic infections are now a major crisis in the whole world due to multidrug resistance. In an effort to search for complementary and alternative remedies, this study evaluated the chemical composition of Dicerocaryum senecioides and Diospyros mespiliformis leaf and fruit extracts, respectively, exhibiting significant in vitro antifungal activity. Ethyl acetate extracts of each plant were screened for antifungal activity against three fungi species: Candida albicans, Trichophyton rubrum and Epidermophyton floccosum using disc diffusion and poisoned food assays. Gas chromatography–tandem mass spectrometry (GC–MS/MS) was used to evaluate the chemical composition after isolation of active bands by thin-layer chromatography-p-iodonitrotetrazolium chloride assay.
Results
The composite crude ethyl acetate extracts of D. mespiliformis and D. senecioides (1:1) exhibited concentration-dependent antifungal potencies. C. albicans was susceptible to the crude extracts up to a minimum concentration of 6.25%. E. floccosum and T. rubrum were more susceptible up to a minimum extract concentrations of 1%. GC–MS/MS analysis of the isolated active TLC bands revealed bioactive compounds including flavonoids (quercetin, luteolin), together with their O-glycosylated counter parts and the C-monoglycosylated flavonoids (vitexin, orientin, isovitexin and isoorientin), terpenoids, esters and other phenolic acids. Some of the compounds were common to both plants.
Conclusion
The findings of this study show that D. senecioides and D. mespiliformis extracts consist of important bioactive compounds to warrant their use in complementary and alternative poly-herbal formulations against fungal infections.
Background
Gradual betterment in therapy of human diseases has greatly increased the life expectancy of immune-supressed individuals. Consequently, proliferation of risk factors is inevitable and favours the onrush of other diseases, especially infectious diseases. Among the diseases, fungal infections in humans represent a substantial quota [1]. Fungal infections are a major problem affecting humans daily and they are many cases of multidrug resistance [2]. Dermatophytosis is a major cause of morbidity related to superficial mycoses, frequently relapsing and predominantly recalcitrant to therapy [3]. Trichophyton, Microsporum, and Epidermophyton are the predominant causative agents of superficial mycotic infections [4]. Fungi have remained among the most problematic pathogens as evidenced by the use of amphotericin B (discovered in 1956) as the “Gold Standard” for antifungal therapy [1]. Due to the rise in the number of people with compromised immune systems due to HIV infection, chemotherapy and diabetes among other ailments, there has been a noticeable increase in the cases of fungal infections in the last few decades [5, 6]. Fungal species that are becoming resistant to available therapies are on the rise in the systems of individuals due to exposure to many drugs (multidrug resistance) [7]. Identifying natural compounds that have the capability to circumvent multidrug resistance with negligible adverse side effects offers a comely option to production of complementary and alternative poly-herbal remedies. In addition, there is a need to unravel novel drug(s) from the natural sources whose mode of action would selectively act on new target with fewer or no side effects [8]. Various ethnic groups use plants in medicinal applications [9]. Plants are a fountainhead of multiplex potent drugs for the pharmaceutical industry owing to the diverse bioactive compounds (secondary metabolites) they possess [10, 11]. Phytocompounds are ultra-practical in managing of some health disorders through their individual, additive, or synergistic action [12]. Phenolics, stilbenoids, tannins, coumarins, saponins, alkaloids, terpenes and terpenoids are some of the bioactive metabolites found in plant species [13]. Polyphenols, of which flavonoids and phenolic acids are the commanding group that have potential health benefits depending on their antioxidant and many antimicrobial activities including antifungal activity. Phenolic compounds are also well known to provide resistance to plant pathogens such as fungal species [14]. Similarly, terpenes and terpenoids have been reported to have significant antifungal activity [15]. Plant secondary metabolites are of utmost importance in the development of new leads and in preparation of therapeutic agents against fungal infections, [16]. Herein, the aim was to investigate the phytochemical composition of leaf extracts of D. senecioides and raw fruit extracts of D. mespiliformis isolated using TLC-directed protocol against Trichophyton rubrum, Epidermophyton floccosum and Candida albicans. Leaf extracts of D. senecioides and raw fruit extracts of D. mespiliformis are widely used to treat fungal infections in ethnomedicine however bioassay directed extraction and phytochemical identification of the active compounds has not been conducted. It is important to screen and identify the compounds for the benefit of the medicinal and pharmaceutical chemists. The identified compounds can be potential lead compounds for antifungal agents that can work against fungal resistance.
Methods
Plant samples and extraction process
Fresh plant materials of D. senecioides were collected from Mberengwa, Zimbabwe, in February 2021 by following WHO guidelines for collecting plants botany 440/540, and voucher specimens were deposited in the university plant library for future reference. The leaves and stems of D. senecioides were cleaned with running tap water and then distilled water, and air-dried under a shade after which the plant material was pulverised. Dried powder, 10 g were macerated in ethyl acetate with intermittent shaking for 72 h. The marc was removed by filtration. The extraction process was done in triplicate using fresh ethyl acetate each time. The menstruum was collected, bulked and concentrated on a rotary evaporator, [17], and dried in a fume-hood. Dried extracts were stored in amber bottles at 4 °C until further analysis. Fresh raw fruits of D. mespiliformis were collected from Mudzi district, Zimbabwe, and were used as fresh samples. The same process was done for D. mespiliformis.
Antifungal assays
Disc diffusion assay against C. albicans
Sterile paper discs saturated with crude extracts separately at 50, 25, 12.5 and 6.25% concentrations were placed using sterilised forceps on the surface of Sabouraud dextrose agar medium inoculated with clinical C. albicans isolates adjusted to 0.5 McFarland standard by suspending the colonies in 5 ml of sterile 0.85% saline and turbidity adjusted to 1.0 × 105 to 1.0 × 106 spores/ml. The plates were incubated overnight at 25 ℃ after which zones of inhibition around the discs were measured. Miconazole was used as the positive control and ethyl acetate only as negative control. Sterilisation of equipment was conducted in an autoclave.
Poisoned food assay against T. rubrum and E. floccosum
Antifungal activity of the crude plant extracts on radial growth of T. rubrum and E. floccosum was evaluated using poisoned agar method. Sabouraud dextrose agar (SDA) was aseptically prepared under sterile conditions. The sterile media were supplemented with varying dilutions of extracts 50%, 25% and 1% mixture (1:1) of both plant extracts. Fifteen millimetres of the poisoned agar was dispensed into sterile triplicate plates and left to congeal. Discs of the test organisms with a diameter of 5 mm were prepared from the growing cultures and placed on the poisoned media. Plain agar and miconazole were used as the negative and positive controls, respectively. The plates were left under incubation at 25 ℃ for 7 days before diameters of fungal colonies were measured. The antifungal effect (percent inhibition of fungal growth) was estimated using the formula:
where Dc is diameter of fungal colony in control plate and Ds is the diameter of fungal colony in test agent plate.
Thin-layer chromatography and thin-layer chromatography-p-iodonitrotetrazolium violet assay
Chemical constituents of the plant extracts were separated on aluminium-backed analytical TLC plates (silica gel F254, 10 × 10 cm, 0.25 mm thickness, Merck). Development was done using solvent systems developed in the laboratory, ethyl acetate/methanol/water (11:6:1.5) for D. senecioides and hexane/acetone (7:3) for D. mespiliformis. A 0.1 mg/ml solution of each extract was separately loaded on TLC plates in a narrow band and eluted using the solvent systems developed in the laboratory. The developed plates were dried in a fume hood to remove traces of solvent. The fungal isolate was shake-incubated separately in Sabouraud dextrose broth at 25 °C for 7 days. To remove mycelia, the culture was filtered through a triple layer gauze cloth. The filtrate was centrifuged for 5 min. A spray emulsion of spores was prepared in dehydrated Sabouraud dextrose agar. Spores were added to 15 ml of SDA solution to give a concentration of approximately 1 × 106 spores/ml. The inoculated medium was sprayed on the developed TLC plates rapidly to avoid solidification. The plates were incubated at 25 °C. Active bands were revealed by spraying with p-iodonitrotetrazolium chloride.
Isolation of the antifungal compounds
The extracts were applied to preparative TLC plates (silica gel F254, 20 × 20 cm, 0.25 mm thickness, Merck) and developed using their respective solvent systems as discussed in previous section. The active bands were marked using Rf values. The bands were scrapped off into separate containers and extracted from the silica gel with their original respective extracting solvents. The containers were centrifuged for 15 min. Resulting supernatants were dried. The isolated active compounds were kept in amber vials in a refrigerator until required for GC–MS/MS analysis.
Gas chromatography–tandem mass spectrometry analysis of active bands
GC–MS/MS analysis of active phytocompounds from D. senecioides and D. mespiliformis was carried out using a PerkinElmer Carus 680 GC-Clarus SQ 8T MS equipped with Elite-5 MS 30 m × 250 µm × 25 μm column. Spectroscopic GC–MS/MS detection by GC–MS/MS was done using an electron ionisation system (70 eV) over the range of 50–650 mass/charge ratio in full scan mode. The temperatures of the ion source and transfer line were 250 °C and 270 °C, respectively. Carrier gas was ultrapure helium with a constant flow rate of 1 mL/min. The column oven temperature initially set at 50 °C, then increased by 5 °C per minute to 150 °C and holding time of about 10 min then increased to 300 °C at a rate of 30 °C per minute. Solvent delay was 5 min. Diluted samples of 1 µL were automatically injected using auto-sampler AS3000 coupled with GC using the split mode. The components were identified by comparing retention times and mass spectra to those of the National Institute of Standards and Technology, NIST14 Mass Spectral (MS) Library Search Program. Compounds with a library match ≥ 90% were considered.
Results
Antifungal assays
Figure 1 represents the in vitro susceptibility of C. albicans to crude ethyl acetate extracts of D. mespiliformis (A) and D. senecioides (B), where 1, 2, 3, 4, and 5 represent 50, 25, 12.5, 6.25% extract concentration and negative control, respectively, while + is positive control miconazole (Tables 1, 2).
Figures 2 and 3 represent the preliminary antifungal susceptibility test results for the two plants against E. floccosum and T, rubrum.
GC–MSMS analysis of active bands and TLC and TLC-p-iodonitrotetrazolium violet assay
Table 3 summarises results obtained in TLC and TLC-p-iodonitrotetrazolium violet assays. A pictorial presentation of the results is given in Fig. 4a-d.
a–d Thin-layer chromatograms and TLC-p-iodonitrotetrazolium chloride results for E. floccosum and T. rubrum. a TLC-Bioautogram (E. floccosum) and chromatogram for D. mespiliformis b TLC-Bioautogram (T. rubrum) and chromatogram for D. mespiliformis. c TLC-Bioautogram (E. floccosum) and chromatogram for D. senecioides. d TLC-Bioautogram (T. rubrum) and chromatogram for D. senecioides
Figure 5a–d shows GC spectra for 4 selected active bands with Rf values of 0.94; 0.88; 0.64 and 0.78 presented as (a) to (d), respectively.
Tables 4, 5, 6 and 7 represent GC–MS/MS phytochemical characterisation of the bioactive bands under study.
Discussion
Poly-herbal medicine is a major part of treatment systems which is gaining popularity everyday due to clinical failures of conventional medicines due to drug resistance fungal strains [2]. The use of herbal medicine is based on practice and concepts emanating from ancient philosophies. In the current era of evidence-based medicine, it is important to accurately assess composition and efficacy of herbal medicine. In the present effort, chemical profiling of antifungal compounds of D. senecioides and D. mespiliformis was done using disc diffusion, poisoned food, p-iodonitrotetrazolium chloride and GC–MS/MS analyses. The study followed the poly-herbal formulation philosophy which has an advantage of achieving greater efficacy at low concentration that is likely to be safe to humans.
Preliminary anti-dermatophytic potency experiments were done using concentrations of 50, 25 and 1% made up of crude extracts of the 2 plants under study mixed in a 1:1 ratio. Radial growth inhibition of E. floccosum colonies was 80.00, 75.00, 20.00% at the aforementioned extract concentrations, respectively, and 73.30% for the positive control. T. rubrum was comparably inhibited at the same concentrations producing percentage inhibition of 73.82, 67.88 and 63.48, respectively, while the control inhibition was 57.50% (Table 2). At 1% concentration of extract, E. floccosum exhibited very low susceptibility compared to T. rubrum although the later had visibly disturbed mycelial growth (Figs. 2 and 3). E. floccosum was generally more susceptible to the plant extracts at higher concentrations than T. rubrum. Generally the extract proved to have potent activity against the test species. The results obtained in this study provide an impetus for further research as very little information is documented on antifungal activity of D. senecioides. Research done by [18], on D. mespiliformis leaves and bark extracts revealed efficacy in the range between 0.02 and 2.5 mg/ml against C. albicans and 0.02–0.16 mg/ml against T. rubrum. Little research has been documented on antifungal activity of raw fruit extracts despite their wide use in traditional practices.
In vitro antifungal activity of ethylacetate extracts of D. senecioides and D. mespiliformis against C. albicans is shown in Table 1, while Figs. 2 and 3 show inhibition of radial growth in E. floccosum and T. rubrum, respectively, by the same extracts. Table 1 gives a numerical summary of the percent inhibition of radial growth in E. floccosum and T. rubrum. In vitro antifungal analysis of the extracts showed that the extract consist of significant antifungal activity. The 1:1 mixture of D. senecioides and D. mespiliformis extracts exhibited greater antifungal activity against C. albicans (Fig. 1) than the standard drug miconazole. Figure 2 shows that at a concentration of 50 and 25%, the efficacy against E. floccosum of the polyherbal mixture was comparable to that of miconazole. No effect was observed at 1%. The polyherbal mixture was very effective against T. rubrum even at a low concentration of 1%. The efficacy was significantly greater (Fig. 3 and Table 2) than that of miconazole.
Using the p-iodonitrotetrazolium chloride assay to screen and isolate the active potions and GC–MS/MS analysis, many bioactive phytochemicals were identified (Fig. 5a–d). The list of compounds identified in the active bands of the extracts through GC–MS/MS are presented in Tables 4, 5, 6, and 7 for bands with Rf values of 0.98, 0.88 (D. senecioides) 0.64 and 0.78 (D. mespiliformis), respectively. Only compounds with match score ≥ 90% were considered. The 0.98 band of D. senecioides consisted of flavonoids and flavonoid glycosides amounting to 10 flavonoid compounds. From D. mespiliformis extract, a total of 6 flavonoid compounds were obtained from the 0.78 band. In a separate phyto-constituent study by Hawas et al. [19] of D. mespiliformis leaf extracts a new acylated flavone isoscutellarein 7-O-(4′′′-O-acetyl)-β-allo- pyranosyl(1′′′ → 2′′)-β-glucopyranoside, together with 8 known flavonoid metabolites, luteolin 3′,4′,6,8-tetramethyl ether, luteolin 4′-O-β-neohesperidoside, luteolin 7-O-β-glucoside, luteolin, quercetin, quercetin 3-O-β-glucoside, quercetin 3-O-α-rhamnoside, and rutin were isolated and identified using spectroscopic data (Ultra Violet, Nuclear Magnetic Resonance, and Mass Spectroscopy). The methylated flavone isolated from methanolic leaf extracts of the plant exhibited potent activity against C. albicans with an inhibition zone of 25 mm [19], while in preliminary antifungal assay in the current study potency of the crude extracts of the plants under study herein against C. albicans was between 15 and 17 mm at 6.25–50% extract concentration. No zones were obtained against C. albicans for both the positive and negative controls (Table 1). Stem bark extracts exhibited potency against C. albicans at 12.5 mg/ml producing a zone of inhibition of 13.00 ± 0.00 mm [10]. The current results further affirm the potency of D. mespiliformis against C. albicans. TLC chromatograms and bioautograms of the raw fruit extracts of D. mespiliformis and stem/leaves extracts of D. senecioides (1:1) mixture (Fig. 4a–d) revealed antifungal compounds with potency against E. floccosum and T. rubrum. Active compounds against E. floccosum had Rf value of 0.88 in D. senecioides and 0.64 in D. mespiliformis while potency against T. rubrum was observed at Rf values of 0.94 and 0.74 in D. senecioides and D. mespiliformis, respectively. GC spectra of these bands are shown in Fig. 5a–d. The 0.94 and 0.78 bands according to GC-MS/MS analysis consisted of flavonoid compounds (Tables 4 and 5). Flavonoids and flavonoid derivatives have been proved to have potent antifungal activity against many fungal pathogens including C. albicans and T. rubrum with efficacies ranging from concentrations as low as 1.95 µg/ml, [20]. The Rf 0.64 band was found to be a mixture of phenolic compounds, aromatic compounds and esters (Table 6). Phenolic compounds are known to provide resistance to plant pathogens, fungal species included [21, 22].
The band at Rf (0.88) was mainly made up of terpenoids, terpenes and methyl esters. Terpenes and terpenoids have antifungal potential. Previous studies have proved that crude terpenoids can inhibit mycelial growth in fungi [23], affect DNA (deoxyribonucleic acid), RNA (ribonucleic acid) and protein synthesis, disrupt cell membrane permeability and also disturb metabolic activity in fungi [23]. Other terpenoid compounds interfere with formation and viability of hyphae and induce morphological alterations in the envelopes of fungi [24]. The biological activity of these compounds in this study is indicative of the medicinal potential of the investigated plants. Inarguably, some of these compounds have different pharmacological activities; hence, the possibility of mutually advantageous conjunction in terms of bioactivity of the phytochemicals determined in the two plants cannot be ruled out as possible contributors to the observed activities [25].
Conclusion
The current investigation results show that D. mespiliformis and D. senecioides ethyl acetate extract consist of bioactive compounds against C. albicans, E. floccosum and T. rubrum, including o-glycosylated and c-glycosylated flavonoids, terpenoids, phenolics and esters. The antifungal activity of the polyherbal mixture as often used in traditional practices was significantly greater or comparable to that of standard antifungal drug. Further studies on isolation of individual active compounds, formulation of poly-herbal alternatives and clinical studies are necessary for the discovery of broad spectrum alternative and complimentary remedies for fungal infections.
Availability of data and materials
All data and material are available upon request.
Abbreviations
- GC:
-
Gas chromatograph
- GC-MSMS:
-
Gas chromatography–tandem mass spectrometry
- TLC:
-
Thin-layer chromatography
- SDA:
-
Sabouraud dextrose agar
- NIST:
-
National Institute of Standards and Technology
- MS:
-
Mass spectral
- DNA:
-
Deoxyribonucleic acid
- RNA:
-
Ribonucleic acid
References
Sanglard D (2016) Emerging threats in antifungal-resistant fungal pathogens. Front Med 3:11. https://doi.org/10.3389/fmed.2016.00011
Venturini TP, Rossato L, Chassot F, Isabel M, Azevedo D, Al-hatmi AMS, Santurio JM, Hartz S (2021) Activity of cinnamaldehyde, carvacrol and thymol combined with antifungal agents against Fusarium spp. J Essent Oil Res 00(00):1–7. https://doi.org/10.1080/10412905.2021.1923580
Ducos R, Fokouo Y, Valere P, Fokou T, Derick C, Mbouna J (2020) Formulation and evaluation of safety and antifungal efficacy of Syzigium Aromaticum -base cream on guinea pigs infected with Trichophyton Mentagrophytes. Pharmacognosy J 12:2. https://doi.org/10.5530/pj.2020.12.54
Almeida F, Rodrigues ML, Coelho C (2019) The still underestimated problem of fungal diseases worldwide. Front Microbiol 10:214
Roemer T, Krysan DJ (2014) Antifungal drug development: challenges, unmet clinical needs, and new approaches. Cold Spring Harbor Perspect Med. https://doi.org/10.1101/cshperspect.a019703
Nikitina LE, Lisovskaya SA, Startseva VA, Frolova LL, Kutchin AV (2022) Biological activity of bicyclic monoterpene alcohols biological activity of bicyclic monoterpene alcohols. BioNanoScience. https://doi.org/10.1007/s12668-021-00912-8
Aldholmi M, Marchand P, Ourliac-garnier I, Pape P, Le S, Ganesan A (2019) A decade of antifungal leads from natural products. Pharmaceuticals 12(4):182. https://doi.org/10.3390/ph12040182
Neves AM, Livya A, Rodrigues M, Marinho ES (2021) Phenolic profile, antioxidant and antifungal activity of extracts from four medicinal plants of the Anacardiaceae family Perfil fenólico, atividade antioxidante e antifúngica de extratos. De quatro plantas medicinais da 2021:1–15
National Center for Complementary and Integrative Health: Complementary, Alternative, or Integrative Health: What’s in a Name? (2016). https://nccih.nih.gov/sites/nccam.nih.gov/files/Whats_In_A_Name_06-16-2016.pdf. Accessed 10 Jan 2021
Olivia NU, Goodness UC, Obinna OM (2021) Phytochemical profiling and GC-MS analysis of aqueous methanol fraction of Hibiscus asper leaves. Fut J Pharmaceut Sci 7:59. https://doi.org/10.1186/s43094-021-00208-4
Cheuka PM, Mayoka G, Mutai P, Chibale K (2017) The role of natural products in drug discovery and development against neglected tropical diseases. Molecules. https://doi.org/10.3390/molecules22010058
Zanna H, Tijani Y, Abubakar S, Modu B, Ali A, Muhammad S (2021) Fungicidal potential of selected plant extracts against human pathogenic fungi. Sci Afr 13:e00864. https://doi.org/10.1016/j.sciaf.2021.e00864
Ga Z, De D (2019) Isolation, characterization and antibacterial activities evaluation of Rumex abyssinicus root bark extracts. Int J Sci Eng Res 7:1912–1927. https://doi.org/10.4172/2329-6836.1000353
Nguyen W, Grigori L, Just E, Santos C, Seleem D (2021) The in vivo anti- Candida albicans activity of fl avonoids. J Oral Biosci 63(2):120–128. https://doi.org/10.1016/j.job.2021.03.004
Hussein HJ (2021) Antifungal efficacy of the crude flavonoid, terpenoid, and alkaloid extracted from Myrtus communis L. against Aspergillus species isolated from stored medicinal plants seeds in the Iraqi markets. J Biotechnol Res Center 15:2
Ansari M, Fatima Z (2019) Natural phenolic compounds. a potential antifungal agent natural phenolic compounds: a potential antifungal agent. Microb Pathogens Strateg Combat Sci Technol Educ 1:1189–1195
Bandiola TM (2018) Screening of medicinal plants for phytochemicals. Int J Pharm 8(1):137–143
Shikwambana N, Mahlo SM (2020) A survey of antifungal activity of selected south african plant species used for the treatment of skin infections. Natl Prod Commun. https://doi.org/10.1177/1934578X20923181
Hawas UW, El-Ansari MA, El-Hagrassi AM (2022) A new acylated fl avone glycoside, in vitro antioxidant and antimicrobial activities from Saudi Diospyros mespiliformis Hochst. ex A. DC (Ebenaceae) leaves. J Biosci 77(9–10):387–393. https://doi.org/10.1515/znc-2021-0291
Saleh M, Aboody A, Mickymaray S (2020) Anti-fungal efficacy and mechanisms of flavonoids. Antibiotics 9:45. https://doi.org/10.3390/antibiotics9020045
Srinivas NR (2019) Combination of flavonoids with azole drugs for fungal infections: key pharmacokinetic challenges. Future Microbiol 14:733–738. https://doi.org/10.2217/fmb-2019-0109
Bakr RO, Amer RI, Fayed MAA, Ragab TIM (2019) A completely polyherbal conditioning and antioxidant shampoo: a phytochemical study and pharmaceutical evaluation. J Pharm Bioallied Sci 11(2):105–115. https://doi.org/10.4103/JPBS.JPBS_214_18
Ludwiczuk A, Skalicka-Woźniak K, Georgiev MI (2017) Terpenoids. Pharmacogn Fundam Appl Strategy. https://doi.org/10.1016/B978-0-12-802104-0.00011-1
Asong JA, Amoo SO, McGaw LJ, Nkadimeng SM, Aremu AO, Otang-Mbeng W (2019) Antimicrobial activity, antioxidant potential, cytotoxicity and phytochemical profiling of four plants locally used against skin diseases. Plants. https://doi.org/10.3390/plants8090350
Nigussie D, Tasew G (2015) In-vitro investigation of fractionated extracts of Albizia gummifera seed against Leishmania donovani amastigote stage. J Clin Cell Immunol 6(6):1–6. https://doi.org/10.4172/2155-9899.1000373
Acknowledgements
The authors would like to thank Research Council of Zimbabwe (RCZ) for GC analysis laboratory work and scholarship grant and Environment Management Agency (EMA), Zimbabwe, for availing to us their GC-MSMS for structure identification.
Plant authentication
Plant samples were collected following WHO guidelines for collecting plant botany 440/540. Plant leaves and stem were identified by comparing information given and pictures with published literature and further authenticated by a taxonomist at the Harare national herbarium. Voucher specimen 02/21 spec 9 was deposited in the herbal specimen store of Bindura University of Science Education, Natural Products section.
Funding
GC MSMS laboratory analysis work was partially funded by Research Council of Zimbabwe.
Author information
Authors and Affiliations
Contributions
All authors participated in the formulated of this study. RZ and PD designed the study and carried out experimental work. LG managed literature and wrote the second draft. RZ wrote the first draft. PD and RZ wrote the final draft. All authors proof read and approved the final draft.
Corresponding author
Ethics declarations
Ethics approval and consent to participate
Not applicable.
Consent for publication
Not applicable.
Competing interests
The authors declare no conflict of interest.
Additional information
Publisher's Note
Springer Nature remains neutral with regard to jurisdictional claims in published maps and institutional affiliations.
Rights and permissions
Open Access This article is licensed under a Creative Commons Attribution 4.0 International License, which permits use, sharing, adaptation, distribution and reproduction in any medium or format, as long as you give appropriate credit to the original author(s) and the source, provide a link to the Creative Commons licence, and indicate if changes were made. The images or other third party material in this article are included in the article's Creative Commons licence, unless indicated otherwise in a credit line to the material. If material is not included in the article's Creative Commons licence and your intended use is not permitted by statutory regulation or exceeds the permitted use, you will need to obtain permission directly from the copyright holder. To view a copy of this licence, visit http://creativecommons.org/licenses/by/4.0/.
About this article
Cite this article
Zhou, R., Dzomba, P. & Gwatidzo, L. Chemical profiling of antifungal Dicerocaryum senecioides and Diospyros mespiliformis extracts using TLC-p-iodonitrotetrazolium violet assay and GC–MS/MS. Futur J Pharm Sci 9, 112 (2023). https://doi.org/10.1186/s43094-023-00565-2
Received:
Accepted:
Published:
DOI: https://doi.org/10.1186/s43094-023-00565-2